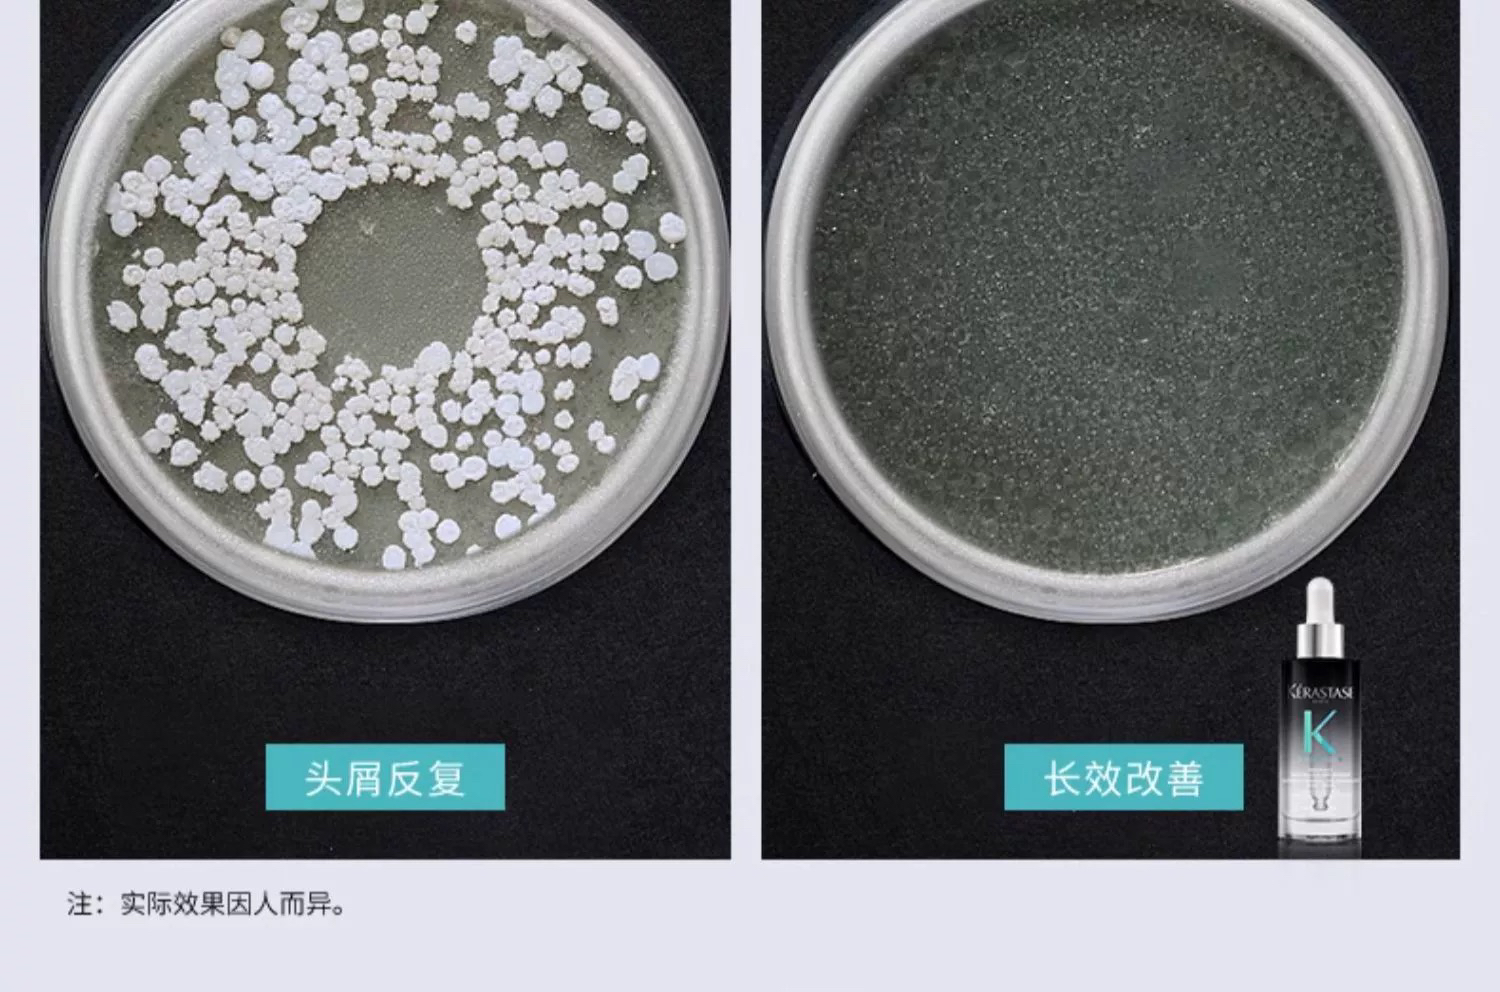

法国 KERASTASE卡诗 元气粉生姜固发/绿色高颅顶控油 头皮护理精华液 30ml/90ml
¥189.00 - 339.00
限时折扣
原价:¥240.00 - 480.00
| 运费: | 免运费 |
| 库存: | 99 件 |
商品详情

- FACEFACE线上商城 (微信公众号认证)
- 扫描二维码,访问我们的微信店铺
- 随时随地的购物、客服咨询、查询订单和物流...






















